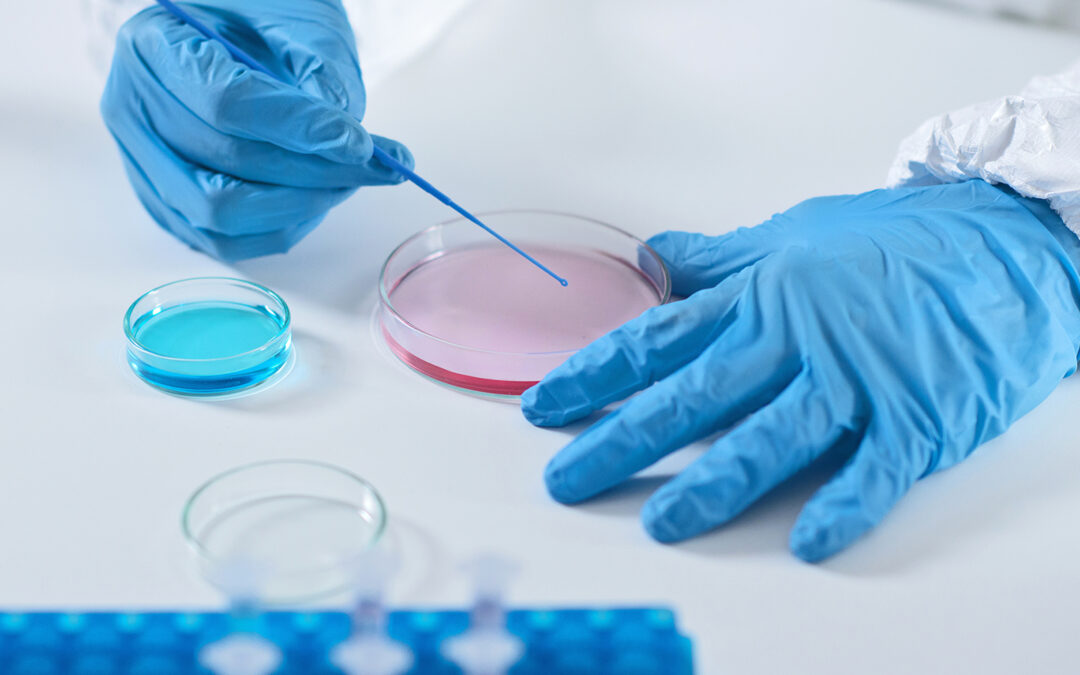

Laboratório de Análises Clínicas
Laboratório de Análises Clínicas
Este site usa cookies para que possamos oferecer a melhor experiência de usuário possível.
As informações dos cookies são armazenadas em seu navegador e executam funções como reconhecê-lo quando você retorna ao nosso site e ajudar nossa equipe a entender quais seções do site você considera mais interessantes e úteis.
O cookie estritamente necessário deve estar sempre ativado para que possamos salvar suas preferências de configuração de cookies.
Se você desabilitar este cookie, não poderemos salvar suas preferências. Isso significa que toda vez que você visitar este site, precisará habilitar ou desabilitar os cookies novamente.
Este site usa o Google Analytics para coletar informações anônimas, como o número de visitantes do site e as páginas mais populares.
Manter este cookie habilitado nos ajuda a melhorar nosso site.
Ative os Cookies estritamente necessários primeiro para que possamos salvar suas preferências!
Mais informações sobre nossa Política de Cookies